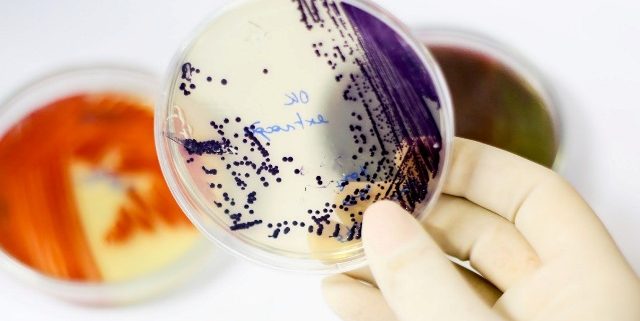

ASCOM
ILMD/Fiocruz Amazônia
ILMD/Fiocruz Amazônia
A Assessoria de Comunicação no ILMD/Fiocruz Amazônia está vinculada ao Gabinete e sua finalidade é atuar por meio da produção de materiais jornalísticos, publicitários e/ou editorial, em mídia impressa e/ou eletrônica, bem como realizar atividades de relações públicas e organização de eventos, tanto para o público interno quanto para o externo, contribuindo para a popularização da ciência através da divulgação cientifica e promoção da imagem do Instituto.

A Assessoria de Comunicação Social do Instituto Leônidas & Maria Deane (ILMD / Fiocruz Amazônia) é o espaço na estrutura organizacional que responde pelas atividades de comunicação interna e externa.
ascom.ilmd@fiocruz.br
Tel.: (92) 3621-2383
Júlio Pedrosa (Assessor)
julio.oliveira@fiocruz.br
Tel.: (92) 3621-2383
Carlos Eduardo Gomes (Jornalista)
carlos.gomes@fiocruz.br
Tel.: (92) 3621-2430
Rua Teresina, 476. Adrianópolis.
Manaus – AM. CEP: 69.057-070.
Tel.: +55 (92) 3621-2323
FALE CONOSCO
Acesse e fale com a gente
Carlos Duarte (ILMD)
Eduardo Gomes (ILMD)
Érico Xavier
Fabiane Vinente (ILMD)
Gerson Toller
Josy Caldas (ILMD)
Sully Sampaio (ILMD)
Nós usamos cookies e outras tecnologias semelhantes para melhorar a sua experiência em nossos serviços, personalizar publicidade e recomendar conteúdo de seu interesse. Ao utilizar nossos serviços, você está ciente dessa funcionalidade.
Accept settingsHide notification onlySettingsWe may request cookies to be set on your device. We use cookies to let us know when you visit our websites, how you interact with us, to enrich your user experience, and to customize your relationship with our website.
Click on the different category headings to find out more. You can also change some of your preferences. Note that blocking some types of cookies may impact your experience on our websites and the services we are able to offer.
These cookies are strictly necessary to provide you with services available through our website and to use some of its features.
Because these cookies are strictly necessary to deliver the website, refuseing them will have impact how our site functions. You always can block or delete cookies by changing your browser settings and force blocking all cookies on this website. But this will always prompt you to accept/refuse cookies when revisiting our site.
We fully respect if you want to refuse cookies but to avoid asking you again and again kindly allow us to store a cookie for that. You are free to opt out any time or opt in for other cookies to get a better experience. If you refuse cookies we will remove all set cookies in our domain.
We provide you with a list of stored cookies on your computer in our domain so you can check what we stored. Due to security reasons we are not able to show or modify cookies from other domains. You can check these in your browser security settings.
We also use different external services like Google Webfonts, Google Maps, and external Video providers. Since these providers may collect personal data like your IP address we allow you to block them here. Please be aware that this might heavily reduce the functionality and appearance of our site. Changes will take effect once you reload the page.
Google Webfont Settings:
Google Map Settings:
Google reCaptcha Settings:
Vimeo and Youtube video embeds:
